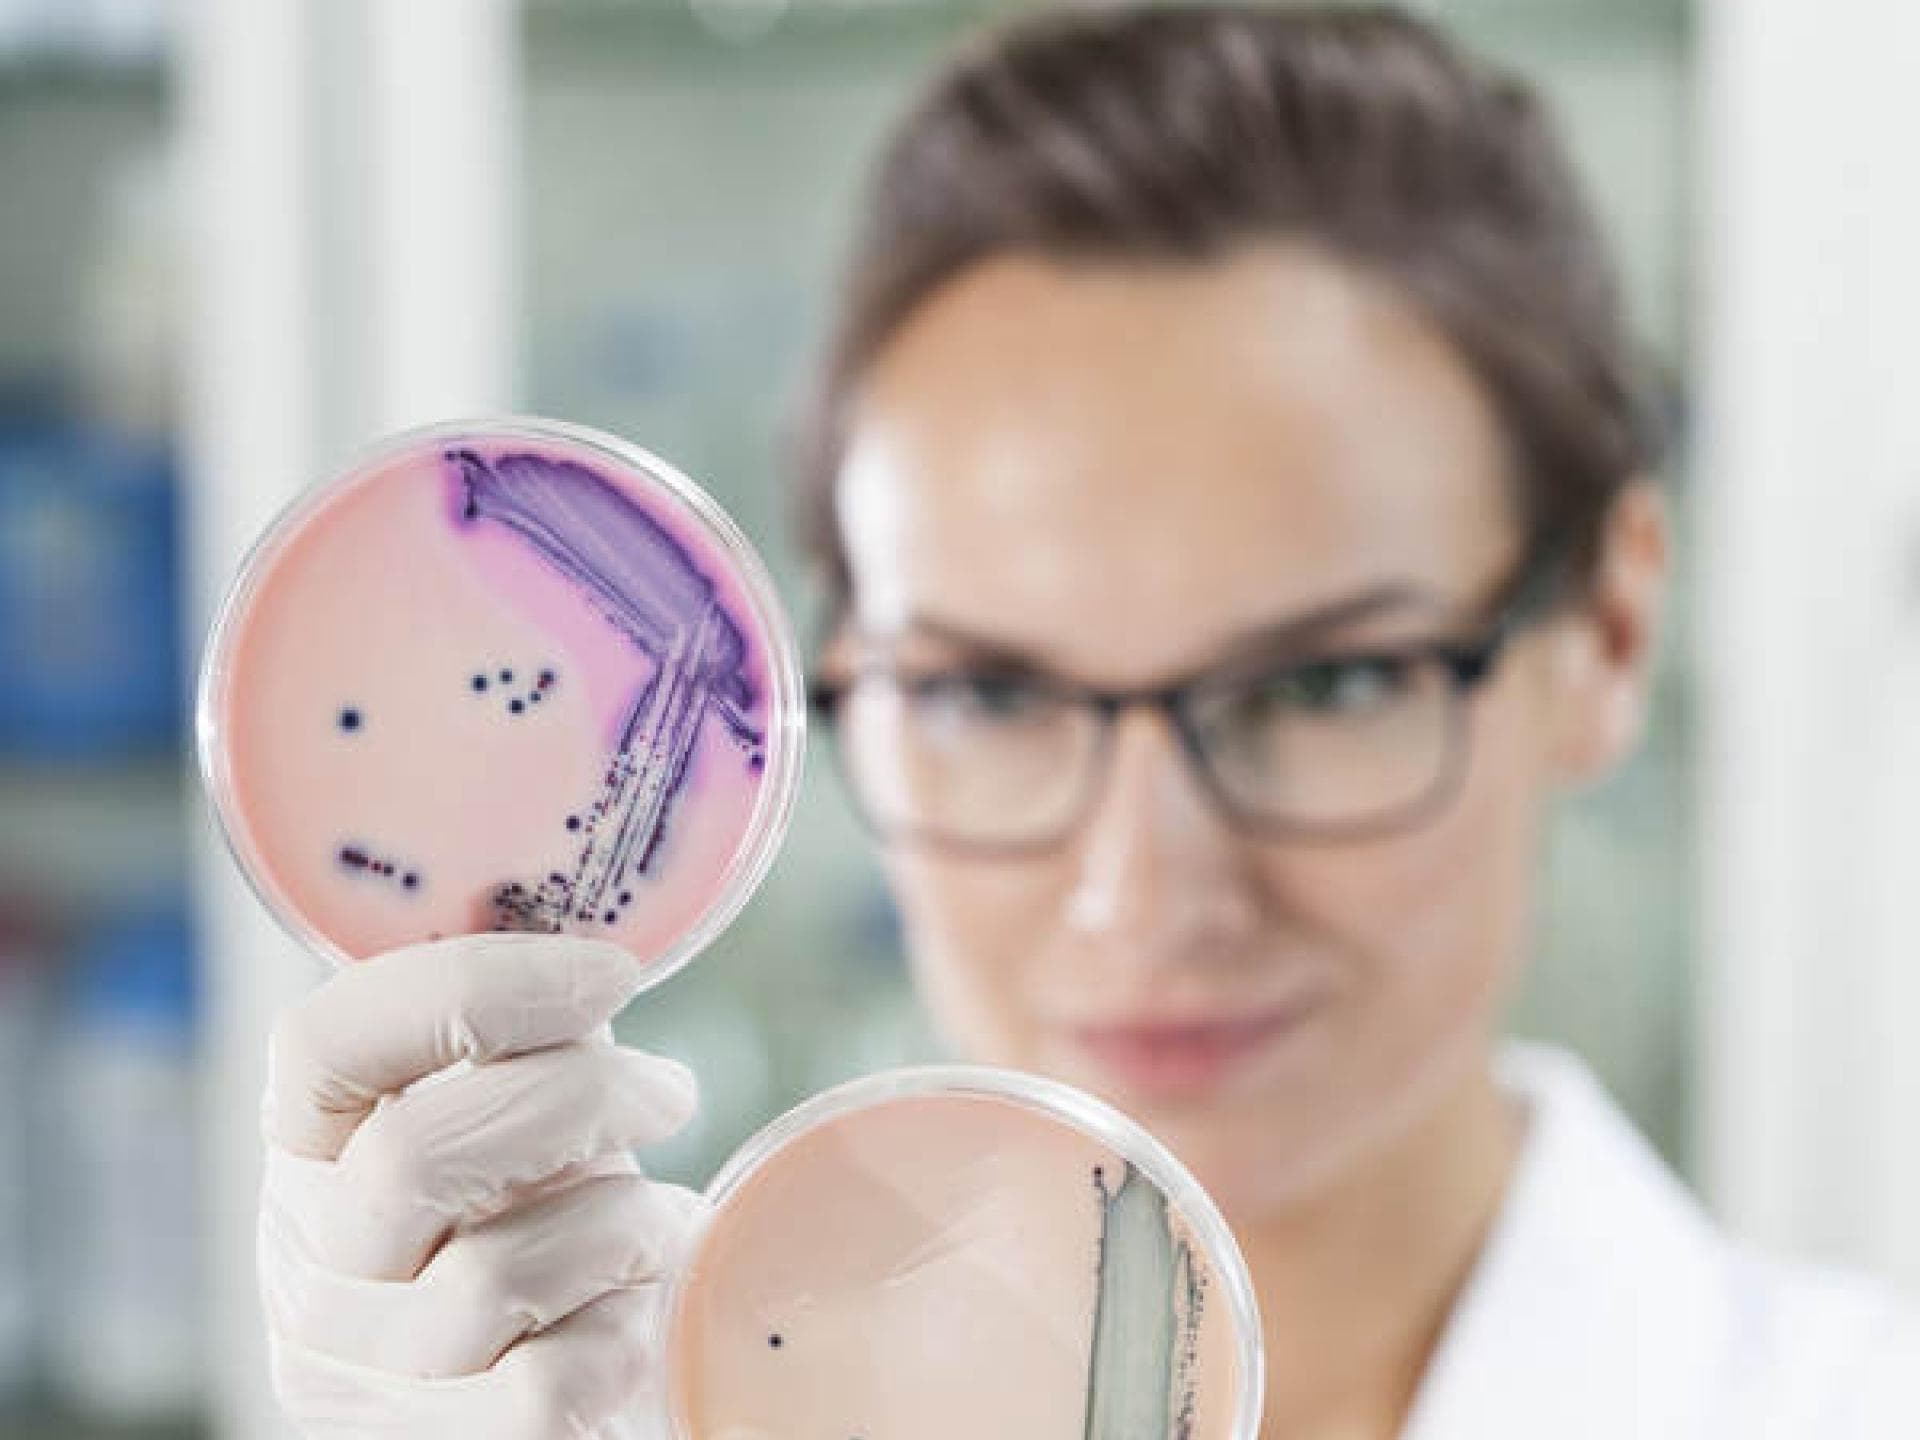
Wie entsteht ein Scheidenpilz?

Die Scheidenflora ist dank der Milchsäurebakterien sauer, so werden erfolgreich Keime und Bakterien bekämpft. Kommt dieses Klima allerdings ins Ungleichgewicht können sich Keime und eben auch Pilze dort ausbreiten und es sich gemütlich machen. Das merkt man dann am Jucken und Brennen im Intimbereich.
